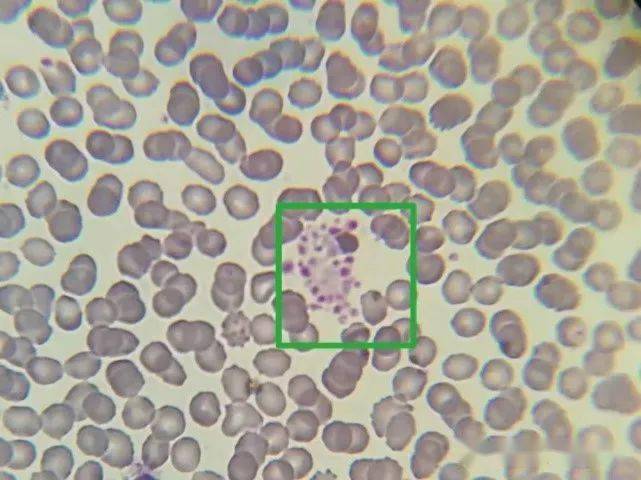
载玻片上,加上盖玻片静置片刻,高倍镜镜检发现有血小板聚集现象(图二

血小板聚集图片

血小板聚集
图片尺寸640x487
如下图仪器显示的血小板分布曲线明显有问题,并提示血小板聚集.
图片尺寸281x282
血液肿瘤血小板聚集巨大血小板在血液涂片照片
图片尺寸296x300
血小板聚集
图片尺寸640x430
血涂片瑞氏染色x1000 血小板聚集由于edta抗凝剂不影响血细胞的形态
图片尺寸1080x1193
其它 hoping的美篇 写美篇镜下plt聚集处理: 1.
图片尺寸2000x2667
edta引起血小板聚集致血小板活化一例
图片尺寸373x419
(末梢血采血不畅过分挤压 时采集血标本中的血小板常常聚集成堆,把
图片尺寸1080x550
一例血小板聚集现象的血小板减少症病例_医学界-助力医生临床决策和
图片尺寸1080x1048
血小板聚集
图片尺寸640x506剂通过阻断纤维蛋白原与gpⅡb/Ⅲa受体结合,抑制adp诱导的血小板聚集
图片尺寸1280x905
一例血小板聚集现象的血小板减少症病例_医学界-助力医生临床决策和
图片尺寸1080x1029呈锯齿状,可能有plt聚集或大血小板干扰,涂片镜检发现是血小板聚集
图片尺寸551x455
下进行了相关比较,如图:枸橼酸钠抗凝管edta-k2管镜下血小板聚集明显
图片尺寸403x405
原创精选血小板聚集后又解聚的案例你遇过吗
图片尺寸600x492
明显异常,报警栏显示血小板直方图分布异常,血小板减少,血小板聚集
图片尺寸660x681
edta引起血小板聚集致血小板活化一例
图片尺寸1039x794
血栓的形成照片
图片尺寸640x814
血小板聚集功能测定及临床意义
图片尺寸800x600
载玻片上,加上盖玻片静置片刻,高倍镜镜检发现有血小板聚集现象(图二
图片尺寸641x480
猜你喜欢:骨髓小粒图片单核细胞图片大血小板图片点彩红细胞图片血小板聚集镜下图片血小板形态图片血小板聚集图谱血小板聚集血小板显微镜下图片血小板的形状图片血小板镜下形态图片血小板卫星现象图片正常血小板图片巨大血小板图片正常血小板形态图片血涂片血小板图片血小板图片卡通图片血小板图片涂片血小板图片血浆血小板聚集图解血小板图片血小板图片止血镜下血小板图片血小板图片手绘图人体血小板图片血小板图片白细胞血小板聚集试验血小板图片显微镜血小板血涂片工作细胞血小板图片壁纸图片情侣一人一半古装裙 仙女原神甘雨表情包沙棘汁一朵花卡通头像大籽本人图片徽宴楼罍街32寸照片挂墙上效果图电子烟大烟圆形边框 软件基督教侯玉杰简介纹身佛花臂